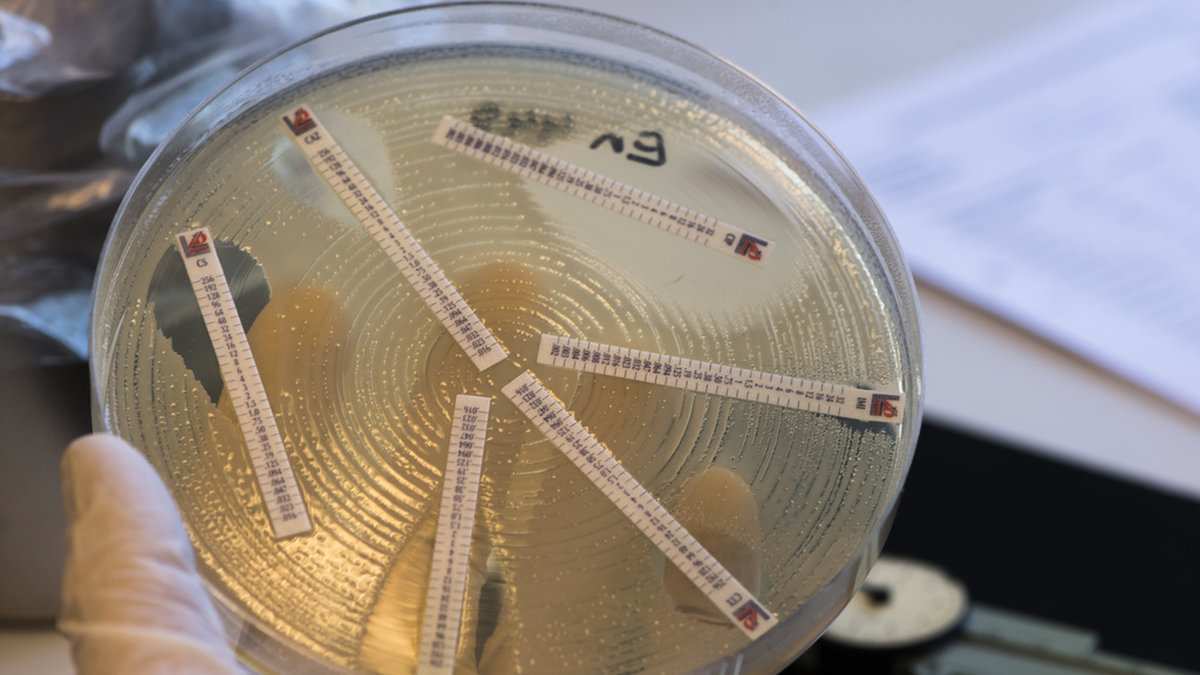

TT är en svensk nyhetsbyrå som grundades 1921. De levererar dagligen nyheter, bilder och videoklipp till medier runt om i Sverige och internationellt. TT är en av de största nyhetsbyråerna i Norden och har ett stort nätverk av journalister och fotografer som rapporterar från hela världen.
TT är en pålitlig källa för nyheter och har ett starkt rykte för att leverera objektiv och korrekt information. De har vunnit flera priser för sin journalistik och är en viktig del av den svenska medielandskapet. TT:s nyheter används av både traditionella medier och digitala plattformar.
TT har en bred rapportering som täcker allt från politik och ekonomi till sport och underhållning. De har också specialiserat sig på att rapportera om vetenskap, miljö och teknik. TT:s nyheter är tillgängliga på flera språk och de har ett dedikerat team som arbetar med att översätta och anpassa nyheter för internationella marknader.

Alltid aktuella och engagerande nyheter. Dygnet runt, året runt.